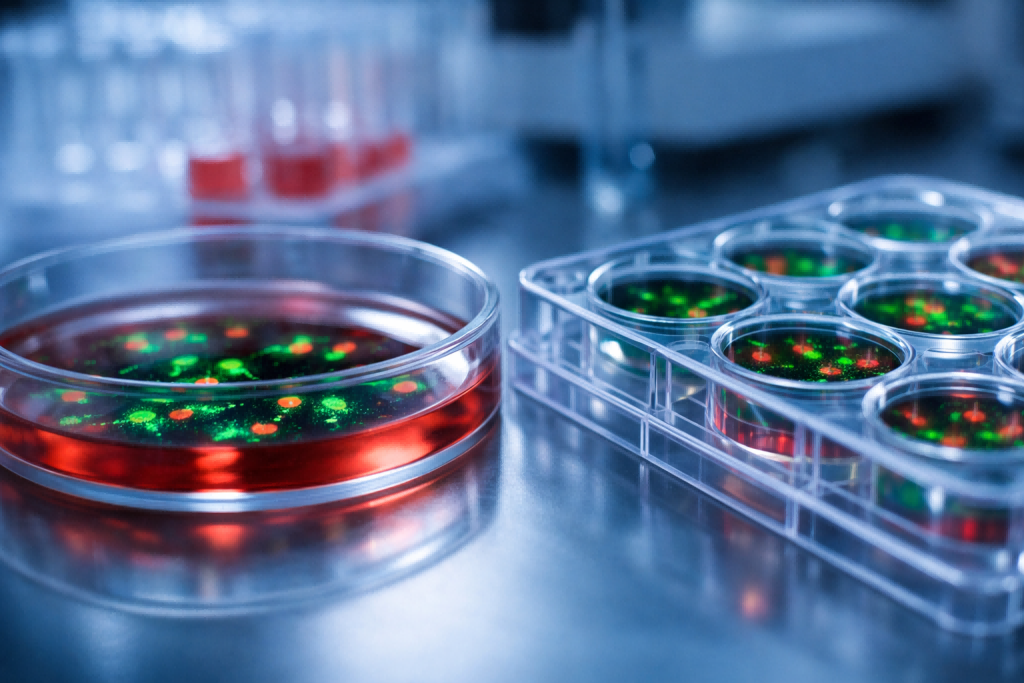
ASGR1 overexpressing cell line

Hot Category
-

Cas9 Stable Cell Lines
Cas9 Stable Cell Lines
Simplify gene editing projects with Cas9 Stable Cell Lines.
-

Immune Molecule&Tumor Antigen Cell Lines
Immune Molecule&Tumor Antigen Cell Lines
Runtogen provides a range of Immune Molecule&Tumor Antigen Cell Lines covering various immune molecules such as PD1, IL2RB, IL6, LILRB, IL4R, IL11, BTLA, CD28, CTLA4, HVEM, LIGHT, CD160, CD8, TNFSF14, etc and various signaling pathways, including EGFR, VEGFR, FGFR, ERBB2, HLA, GPRC5D, ROR1, CLDN18.2, GPC3, Siglec15, LAG3, B7H3, DLL3, B7H4, B7H6, FAP, and more. Additionally, we also offer Immune Molecule&Tumor Antigen Cell Lines that stably express various fluorescent proteins or luciferase, offering scientists customizable options for their research needs.
-

Knockout Cell Lines
Knockout Cell Lines
Runtogen’s Knockout cell bank covers 10,000+ genes, including 8 signal pathways, 10+ drug development sectors, 200+ common diseases and popular research fields. 5,000+ pre-made KO cell lines in stock.
-

Luciferase Cell Lines
Luciferase Cell Lines
Luciferase Stable Cell Lines can stably express firefly luciferase with high specificity and sensitivity. Runtogen provides low-passage Luciferase stable cell lines whcih are tested for luciferase activity and have good tumorigenicity. Our luciferase cell lines offer both in vitro luminescent assays and in vivo live animal bioluminescent imaging.
-

Reporter Cell Lines
Reporter Cell Lines
Runtogen offers more than 200 reporter cell lines, encompassing various signaling pathways such as NF-κB, NFAT, GPCR, cAMP, etc., utilizing different reporter genes like GFP, RFP, luciferase, etc.